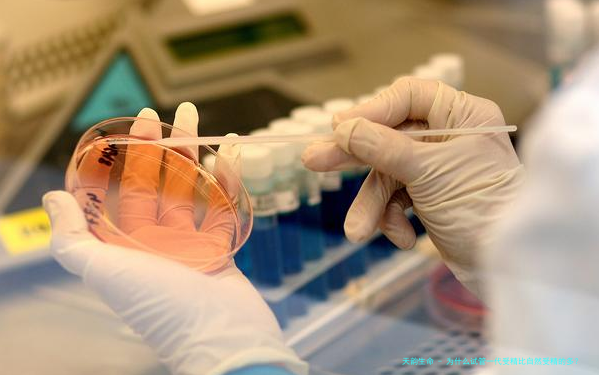

【为何试管一代受精比天然受精的多?试管能够选择出质量高的卵子】试管一代受精比天然受精的多,是因为在受精过程中,医疗可监控和改良受精环境,保障卵子和精子在最佳情况下结合,这一类精细的控制和管理能帮助提高受精成功率。且试管受精相比自然受精成功率高的原因可能是由于精卵质量质量更好,在试管受精过程中,医疗团队可对卵子和精子进行筛选,选择最具生育潜在能力的卵子和精子进行结合,从而提高受精成功概率。
因何试管一代受精比当然受精的多
试管一代受精比自然受精的多,是因为一代试管技术很大程度里可以帮助治疗一些影响受精的病症,例如输卵管不通、精子数量或质量问题、卵巢功能异样等。
通过试管受精,医生可以在体外将精子和卵子结合,然后将受精卵植入女性子宫,帮助那些没有办法自孕的夫妇实现生育心愿。所以试管婴儿技术为许多试管婴儿助孕夫妇提供了一种有效的生育途径。
试管一代受精结果一般来说在受精后的约10至14天内可以进行血清孕酮检测来认定是否是怀孕。这便是因为胚泡植入后,会开始排出孕酮,而孕酮水平的变迁可以作用于评价是否是成功受孕。
另外跟着现代社会中晚婚晚育的趋向,对对于一些年龄较大的夫妻来说,自然受孕的成功率可能会减低,而一代试管受精技术可以帮助他们打败年纪因素的影响,提高受孕成功率。
试管受精比自然受精多是否为因为精卵质量优
试管受精比自然受精多可能因为精卵质量好,在试管受精过程中,医生可以更较真地检查筛选最健康、比较有发展潜力的精子和卵子,然后进行体外培育,以选择最优质的胚胎进行植入。
这一类精细的检查筛选和培育过程有助于提高精卵质量,从而增加了试管婴儿的成功率。因此精卵质量好诚然多是导致试管婴儿成功率较高的1个首要因素。
对对于一些受孕障碍或不育症患者来说,他们可能存在着特定的生殖问题,如精液质量不好、卵子质量降低等,这会导致自然受孕难题。此时优孕行建议可以选择通过做一代试管婴儿,解决这些问题,进而提高受孕成功率。
转载请注明出处。